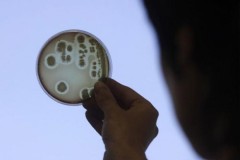

Một khám phá mới đây cho thấy những loài vi khuẩn đã tồn tại trên Trái Đất từ 3,7 tỷ năm trước, sau 1 tỷ năm từ khi Trái Đất được hình thành.
Trong một nỗ lực tìm kiếm những dạng sống động vật đầu tiên trên Trái Đất, các nhà khoa học căn cứ vào những dất vết hóa thạch như dấu chân, vết trầy xước, hang ổ... của những loài động vật. Một số nhà khoa học tuyên bố tìm thấy bằng chứng động vật đã tồn tại từ hơn một tỷ năm trước, nhưng các kết quả này vẫn gây tranh cãi. Ngoài ra, còn một số dấu vết hóa thạch từ kỷ Ediacaran cho thấy những loài động vật thân mềm đã sinh sôi và tồn tại ở thời gian này.
Nhà hải dương học Giulio Mariotti từ Đại học bang Louisiana cùng các đồng nghiệp của mình, đã tìm ra dấu vết sự sống từ kỷ Ediacaran và nhận thấy rằng đó có thể là vi khuẩn. Kết quả này được công bố gần đây giải thích bởi những bằng chứng đáng tin cậy về thế giới sự sống thuở ban đầu.

Một hóa thạch cho thấy vết tích của loài Dickinsonia Costa từ kỷ Ediacaran. (Ảnh: Wikipedia Commons).
Nhiều hóa thạch vi khuẩn trong kỷ Ediacaran được tìm thấy trong những dạng địa hình như rặng núi nhỏ hay các miệng hố, chúng là bằng chứng cho sự tồn tại của vi khuẩn trong thời cổ đại. Thảm vi khuẩn đã sinh sôi mạnh trong thời tiền Cambri – thời điểm trước khi động vật phát triển đa dạng, tuy nhiên thảm vi khuẩn đã không phát triển ở các vùng biển, khi những động vật ăn cỏ sau này sẽ phá hủy cấu trúc của chúng.
Mariotti và các đồng nghiệp đã thực hiện một thí nghiệm để tạo ra những đường mòn và rãnh, hố tương tự như ở các nơi tìm thấy dấu vết hóa thạch. Họ đã đặt vi khuẩn nằm dọc theo cát ở đáy thùng nước và tạo sóng nhân tạo trên mặt nước. Số vi khuẩn lớn hơn cát nhưng ít dày đặc hơn. Mật độ thấp hơn cho phép chúng di chuyển được trên cát với mức năng lượng tiêu thụ thấp.
Việc sử dụng mức năng lượng thấp là rất quan trọng, vì khi sử dụng nhiều năng lượng, chúng có thể làm mất dấu vết để lại. Những dấu vết hóa thạch để lại hầu hết là những đường đi của chúng vẽ nên khi di chuyển trên nền cát.
Tuy nhiên, nghiên cứu này không khẳng định những dấu vết ban đầu đó được gây ra bởi vi khuẩn, mà cho chúng ta một lời giải thích rõ ràng hơn về những vết tích để lại. Nếu trong tương lai, các nhà khoa học tìm thấy những dấu vết hóa thạch khác từ kỷ Ediacaran hay sớm hơn, chúng ta sẽ có những giả thuyết chính xác hơn về sự sống trong thời kỳ này.
Các hóa thạch của những loài vi khuẩn trong kỷ Ediacaran (trái) và vết tích được tái tạo lại từ thí nghiệm trong phòng thí nghiệm của các nhà khoa học (phải). (Ảnh: SEPM).
Chúng ta có thể phân biệt được dấu vết để lại của những loài sống khác nhau, dựa vào việc đường đi của chúng so với nguồn thức ăn hay kẻ thù ở một vị trí nào đó. Những vết tích để lại trong kỷ Ediacaran đều là những trầm tích ba chiều phức tạp.
Sự hình thành và phát triển của những dạng sống đầu tiên trên Trái Đất là rất quan trọng để cho chúng ta thêm hiểu biết về sự sống trên các hành tinh khác. Chúng ta bây giờ cần những bằng chứng cụ thể hơn về sự sống ở thời điểm này. Mariotti cùng nhóm của ông đang nỗ lực tìm kiếm và thực hiện nhiều thí nghiệm hơn nhằm phân biệt hóa thạch của từng loài động vật khác nhau dựa vào vết tích để lại của chúng.
Theo khampha